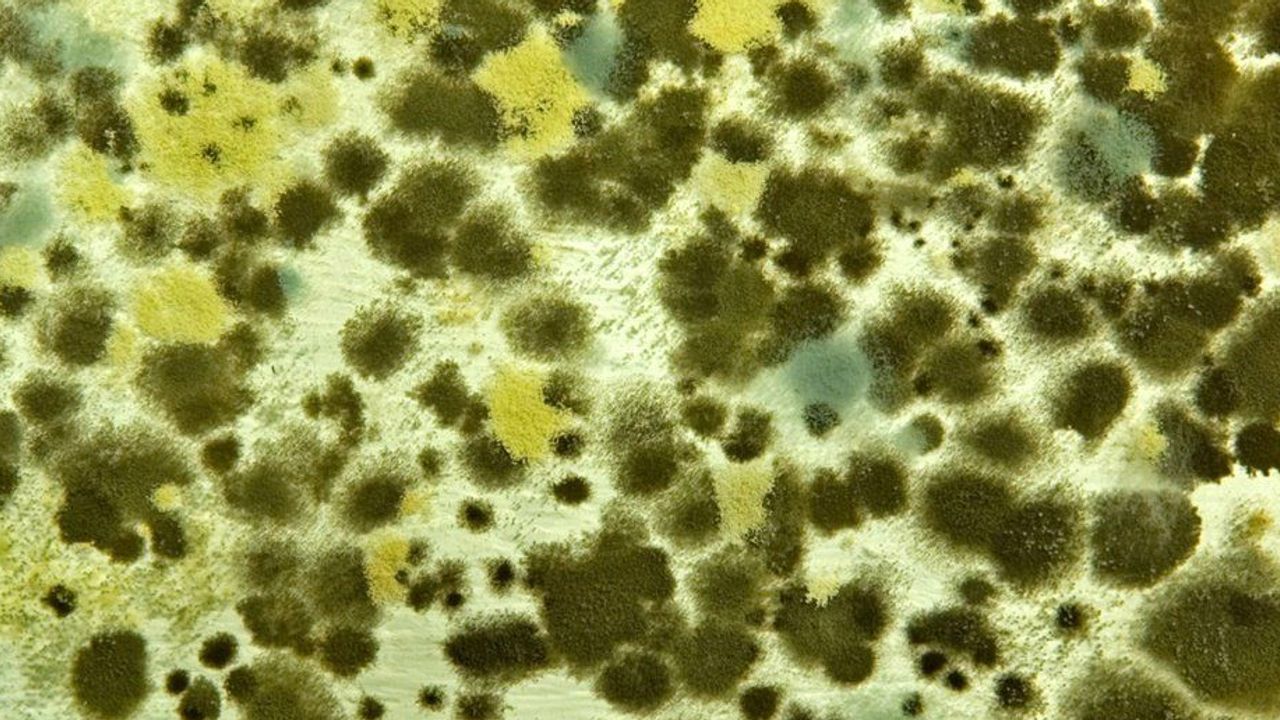

Havaların serinlemeye başladığı, kapalı alanlarda daha fazla vakit geçirdiğimiz sonbahar ayları, birçok kişi için alerjik hastalıkların yeniden alevlendiği bir dönem anlamına geliyor. Bahar aylarında polenler nedeniyle artan alerjik şikayetler, sonbaharda bu kez küf mantarları, ev tozu akarları ve nemli ortamlar yüzünden yeniden ortaya çıkıyor.
Alerjinin kimi zaman yıl boyu devam edebilen bir durum olduğunu belirten Medline Adana Hastanesi Göğüs Hastalıkları Uzmanı Dr. Mustafa Faysal Baysal, bu problemin erken tanı ve uygun tedaviyle kontrol altına alınabileceğini söyledi.
Küf mantarları ve ev tozu akarları alerjiyi tetikliyor
Sonbaharla birlikte hava sıcaklıklarının düşmesi ve yağışların artmasının iç mekanlarda nem oranını yükselttiğini belirterek, Dr. Baysal, "Bu durum da küf mantarlarının ve ev tozu akarlarının çoğalması için elverişli bir ortam oluşuyor. Küf mantarları genellikle banyo, mutfak, bodrum gibi nemli bölgelerde duvarlarda veya mobilya arkasında görünmeden çoğalabiliyor. Solunum yoluyla bu mantar sporlarına maruz kalan kişilerde burun akıntısı, hapşırık, geniz kaşıntısı, gözlerde sulanma ve öksürük gibi belirtiler ortaya çıkabiliyor. Ev tozu akarları ise özellikle yünlü halılar, pelüş oyuncaklar, yatak ve yastık içlerinde yaşıyor. Havalandırılmayan odalarda biriken bu mikroskobik canlılar da solunum yoluyla alerjik reaksiyonları tetikleyebiliyor. Bu sorundan korunmak için, evlerin sık sık havalandırılması, halıların düzenli olacak şekilde süpürülmesini ve yatak takımlarının yüksek ısıda yıkanması gerekiyor" dedi.
Kapalı alanlar alerjiyi riskini artırıyor
Havanın soğumasıyla birlikte daha fazla kapalı ortamlarda vakit geçirmenin alerjik kişilerin riskini arttırdığını söyleyen Baysal, "Okulların açılması, iş yerlerinde uzun saatler geçirilmesi ve evde geçirilen zamanın artması, alerjenlerle temas süresini uzatıyor. Bu da burun tıkanıklığı, sürekli hapşırma, boğazda yanma ve öksürük gibi şikâyetlerin sıklaşmasına neden oluyor. Evlerde kullanılan ısıtıcı sistemleri de ortam havasını kurutarak burun ve boğaz mukozasının savunma direncini azaltabiliyor. Bu durum hem alerjik reaksiyonlara hem de üst solunum yolu enfeksiyonlarına zemin hazırlıyor. Bu nedenle yaşam alanlarının düzenli havalandırılması, filtrelerin temizlenmesi ve ortam nem dengesinin korunması büyük önem taşıyor" şeklinde konuştu.
Burun tıkanıklığını hafife almayın
Uzun süren burun tıkanıklığı, geniz akıntısı veya geçmeyen öksürüğün sadece basit bir soğuk algınlığı olarak değerlendirilmemesi gerektiğini kaydeden Baysal, "Bu tür belirtiler kronikleşirse alerjik rinit veya sinüzit gibi rahatsızlıklara dönüşebiliyor. Bu durumda alerji belirtileri yaşam kalitesini düşürmeden önce bir göğüs hastalıkları veya alerji uzmanına başvurmak önem taşıyor" diye konuştu.
Dr. Mustafa Faysal Baysal, sonbahar alerjilerini önlemek veya hafifletmek için şu önerileri sıraladı:
"Evde nem oranını yüzde 40-50 arasında tutun; gerekirse nem alıcı cihaz kullanın
Yatak, yastık ve yorganları haftada bir 60 derecede yıkayın
Halı, perde ve pelüş oyuncakları mümkün olduğunca azaltın
Pencereleri sabah erken veya gece geç saatlerde kısa süreli açarak evi havalandırın
Küf oluşan bölgeleri sirke veya özel temizlik ürünleriyle temizleyin
Gerekirse doktor tavsiyesiyle alerji ilaçları veya burun spreyleri kullanın
Evcil hayvan tüyleri alerjiyi tetikleyebileceği için hayvanla aynı odada uyumamaya özen gösterin."